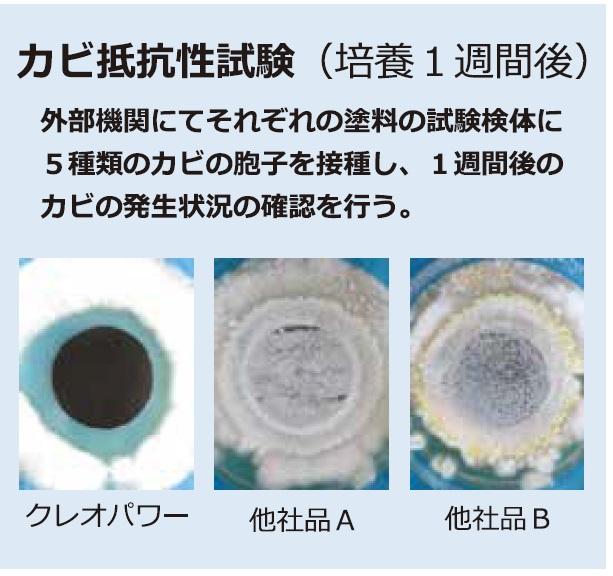

Atributos
JapanLugar del origen
PoliuretanoMateria prima principal
Revestimiento de maderaAplicación
W-5Número de Modelo
Recubrimiento líquidoEstado
Unidades de venta:Artículo individual

Cada pago que realice en Alibaba.com está protegido mediante cifrado SSL estricto y protocolos de protección de datos PCI DSS.

Solicita un reembolso si tu pedido no se envía, falta o llega con problemas en el producto.